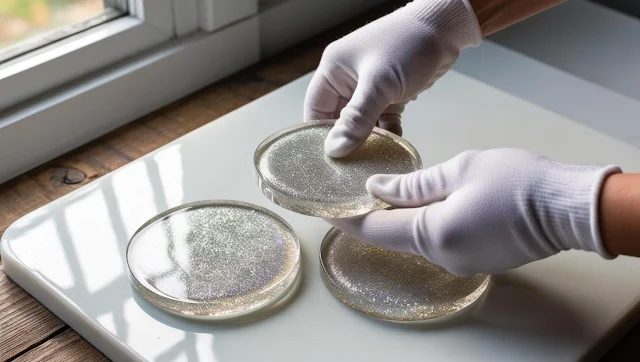

How to Make Glitter Resin Coasters: A DIY Guide | The Craft Safe
Hey there, craft enthusiasts!
Welcome back to The Craft Safe blog. Today, we're going to create something truly special: dazzling glitter resin coasters! These beauties are not only practical for protecting your furniture but also add a personalized touch of sparkle to your home decor. Resin art might seem intimidating at first, but trust me, it's easier than you think.
This step-by-step guide will walk you through the process, and you'll be amazed at the professional-looking results you can achieve, even if you're a complete beginner to resin art! Plus, you'll find all the supplies you need, including our fabulous selection of glitter, in my Etsy shop, The Craft Safe.
Why You'll Love This Project:
- Customization: You can create coasters that perfectly match your style and decor.
- Unleash Your Creativity: Experiment with different glitter colors, shapes, and combinations.
- Great for Gifts: Handmade resin coasters make thoughtful and unique gifts.
- Affordable Luxury: Add a touch of elegance to your home without breaking the bank.
What You'll Need:
- Epoxy Resin: (e.g., ArtResin, Pro Marine Supplies, or a similar brand. I recommend a clear, UV-resistant resin for coasters.)
- Hardener: (Usually comes with the resin)
- Silicone Coaster Molds
- Glitter: Here's where the fun begins! Choose your favorite colors and types from The Craft Safe. For this project, I recommend a mix of fine and chunky glitter for added dimension. Blue Dreamy Glitter Mix - Chunky, Shade-Shifting, Perfect for Crafts, Resin Art & Tumblers
- Mixing Cups: (Disposable plastic cups work well)
- Stir Sticks: (Popsicle sticks or plastic stirrers)
- Gloves: (Protect your hands from the resin)
- Heat Gun or Torch: (To remove air bubbles)
- Measuring Tape or Ruler
- Optional: Pigments, alcohol inks, dried flowers, or other embellishments to add to your resin.
Let's Get Crafting: Step-by-Step Instructions
Step 1: Prepare Your Workspace
- Work in a well-ventilated area.
- Cover your work surface with a disposable plastic sheet or silicone mat to protect it from spills.
- Gather all your supplies and make sure they are within easy reach.
Step 2: Measure and Mix the Resin
- Safety First: Put on your gloves!
- Carefully measure equal parts of resin and hardener according to the manufacturer's instructions. The ratio is usually 1:1, but it's crucial to follow the specific instructions for your brand of resin.
- Pour the resin and hardener into a mixing cup.
- Mix Thoroughly: Stir slowly and consistently for 2-3 minutes, scraping the sides and bottom of the cup to ensure everything is well combined. Avoid whipping or stirring too fast, as this can introduce air bubbles. Proper mixing is key to a successful resin project!
Step 3: Add Your Glitter!
- Once the resin is mixed, it is time for the best part, adding the glitter!
- If you're using multiple colors or types of glitter, divide the resin into separate cups for each color.
- Add your chosen glitter to the resin and stir gently to combine.
- Start with a small amount of glitter and add more until you achieve the desired level of sparkle. There is no set amount so you can add as little or as much glitter as you want, it is your creation after all!
- Pro Tip: For a layered effect, let the first layer of resin with glitter cure slightly before adding a second layer with a different glitter or color. You can also create stunning effects by mixing fine glitter with chunky glitter for added texture and dimension. Check out our The Ultimate Glitter Guide: Types, Uses & More | The Craft Safe blog post for more glitter inspiration!
Step 4: Pour into Molds
- Carefully pour the glitter-resin mixture into your silicone coaster molds.
- Fill the molds to the top, or slightly overfill if you want a domed effect.
- Tip: If using multiple colors, you can create patterns or designs by pouring different colors into different sections of the mold. Try swirling colors together with a toothpick for a marbled effect!
- Optional: Add other embellishments like pigments, alcohol inks, or dried flowers now.
Step 5: Remove Air Bubbles
- Use a heat gun or a small torch to gently heat the surface of the resin. This will help any air bubbles rise to the surface and pop.
- Safety Note: Be very careful when using a heat gun or torch. Keep it moving and don't hold it too close to the resin, or you could scorch it.
- You can also use a toothpick or a pin to pop any stubborn bubbles.
- Do this step fairly quickly after pouring to avoid the resin setting before all bubbles are removed.
Step 6: Cure and Demold
- Let your coasters cure in a dust-free environment for the amount of time recommended by the resin manufacturer. This is usually 24-72 hours.
- Important: Do not touch or move the coasters while they are curing.
- Once the resin is fully cured, gently demold your coasters by carefully peeling back the silicone molds.
Step 7: Admire Your Work!
You've done it! Your beautiful, handmade glitter resin coasters are ready to use or gift.
Tips and Variations:
- Color Combinations: Experiment with different glitter color combinations to create unique effects. Try monochromatic, complementary, or rainbow palettes. For a truly dazzling effect, use holographic glitter or iridescent glitter from our shop!
- Layering: Create depth and dimension by layering different types of glitter or adding a clear layer of resin on top.
- Personalization: Add initials, names, or small charms to personalize your coasters.
- Finishing Touches: If needed, you can sand the edges of your coasters with fine-grit sandpaper for a smooth finish. You can also add a top coat of resin for extra shine and protection.
Share Your Creations!
I'd love to see your finished glitter resin coasters! Share your photos on social media and tag us using #TheCraftSafe. You might even be featured on our page!
Shop The Craft Safe:
Head over to our Etsy shop, The Craft Safe, to explore our dazzling collection of glitter and start your next glitter adventure today!
What are your favorite types of glitter to work with? Let me know in the comments below! And don't forget to share your glittery creations with us on social media using #TheCraftSafe. I can't wait to see what you make!
Follow us on social media
- Instagram: https://www.instagram.com/thecraftsafe
- Pinterest: https://www.pinterest.com/thecraftsafe

Comments
Post a Comment